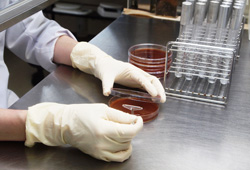
品質管理部門による厳しいチェック

金秀バイオでは、原料の生産・調達から最終商品化までを自社一貫体制を実現しています。
すべての工程において責任を持って、日々厳しい品質管理を行うことで、安心・安全な健康食品の製造が可能になると私たちは考えます。
金秀バイオでは、(財)日本健康・栄養食品協会よりGMP認定工場としての認証を2011年6月に受けました。
GMPとは、Good Manufacturing Practiceの略で、製造管理及び品質管理規則のことを言い、健康食品の製造に対して、規格を設けることにより、より安全・安心な製品を製造することを目的に自主基準として規格化されたものです。
金秀バイオでは、沖縄県でいち早く国際規格の品質マネジメントシステムISO9001・2000、ISO9001・HACCPの認証を取得。
さらに、2006年1月に食品の安全性・信頼性をテーマに登場した「食品安全マネジメントシステム」であるISO22000の認証を取得しました。
金秀バイオでは、信頼できる素材しか使用しません。
また、農薬や化学肥料を一切使わずに生産された、有機農産物を使用することにも取り組んでおり、有機農産物加工食品を取扱う工場である、有機JAS認定工場として認定されています。

お客様に安心・安全な商品をお届けできるよう、原料の生産から製造、包装、出荷に至るまでの記録を保全し、万が一の場合には速やかに原因追究できる体制を整えています。
工場内は各区域で行う作業内容より清浄度を区分し、その清浄度により下の表のように3つに区分されています。
各区域は、それぞれ着衣や履物等の区別を行う等の管理を行い、必要とする清潔度を守っています。
| 区分 | 該当する作業室 |
|---|---|
| 清浄度区分1 |
・計量充填室 ・粒検査室 ・カプセル充填室 ・打錠室 ・コーティング室 ・第1分包室 ・第2分包室 ・計量室 ・造粒室 ・凍結乾燥室 ・混合室 |
| 清浄度区分2 |
・レトルト充填室 ・仕上げ室 ・小分け原料室 ・包装室 ・スプレードライ室 ・抽出濃縮室 ・アルコール抽出室 ・発酵・抽出室 ・培養・乳化室 ・化粧品原料製造室 ・接触包材資材庫 ・半製品倉庫 ・製品原料倉庫 |
| 清浄度区分3 |
・男子更衣室 ・女子更衣室 ・トイレシャワー室 ・洗濯乾燥室 ・洗浄室 ・乾燥室 ・商品管理室 ・保冷庫 ・梱包室 ・倉庫 ・購買倉庫 ・お茶原料室 ・粉砕室 ・焙煎室 ・菌糸体培養室 |

工場内入室時には作業着に着替えますが、更衣室も脱衣所と着衣所に分け、服装からの異物の持ち込みを防止しています。作業着に着替えた後は、手洗い、アルコール殺菌を行い、入室します。
また、必要箇所には、エアシャワーを設け、作業服に付着したゴミ等を取り除く対策を行っています。

口に入る製品が暴露されるような作業場所では、入室前に前室で作業服のチェックを行い、マスク、手袋等を着用し、清潔な状態で作業が出来るようになっています。
また、室外より室内にフィルターを通った空気を吹き込むことにより、室内を陽圧にし、室内の環境を保っています。

品質を保つため、空調完備された室内で保管しております。

さまざまな品質管理を取り入れ、管理する社員の教育も徹底して行っています。
品質管理部門においては工程毎に外観、一般生菌数、大腸菌群、水分活性等の確認を行うなど、製品が出来上がるまで複数回の工程管理を行い、安全・安心な製品を提供できるような体制になっております。